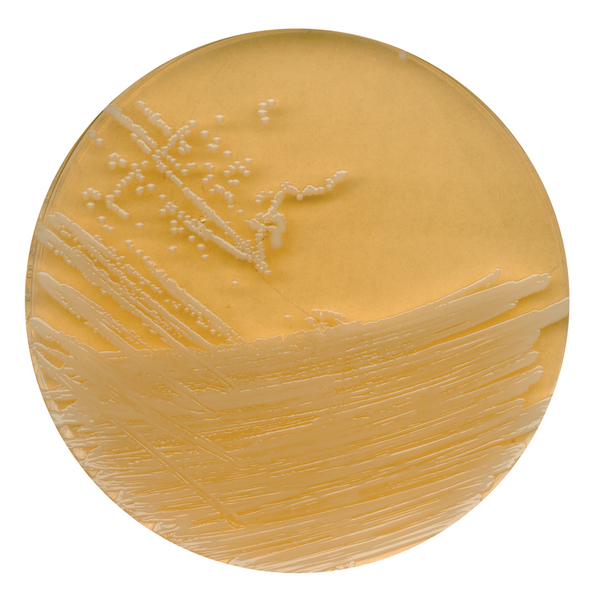
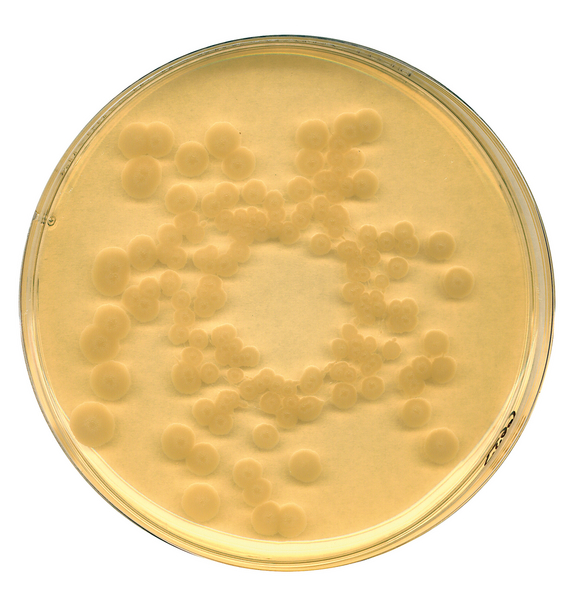

Merck
Merck is a leading science and technology company in healthcare, life science and performance materials. Around 50,000 employees work to further develop technologies that improve and enhance life from biopharmaceutical therapies to treat cancer or multiple sclerosis, cutting-edge systems for scientific research and production, to liquid crystals for smartphones and LCD televisions. At Merck Millipore, we believe that quality in means quality out. That's why our reagents, chemicals and labware are subjected to stringent controls during development and production to ensure reliable and reproducible results. Whether for analysis or synthesis, complex or routine applications, research or production, or even cleaning or monitoring, we give you a choice of over 30,000 premium chemicals and reagents to facilitate your daily work. Founded in 1668, Merck is the world's oldest pharmaceutical and chemical company. Merck, Darmstadt, Germany holds the global rights to the Merck name and brand. The only exceptions are the United States and Canada, where the company operates as EMD Serono, MilliporeSigma and EMD Performance Materials.